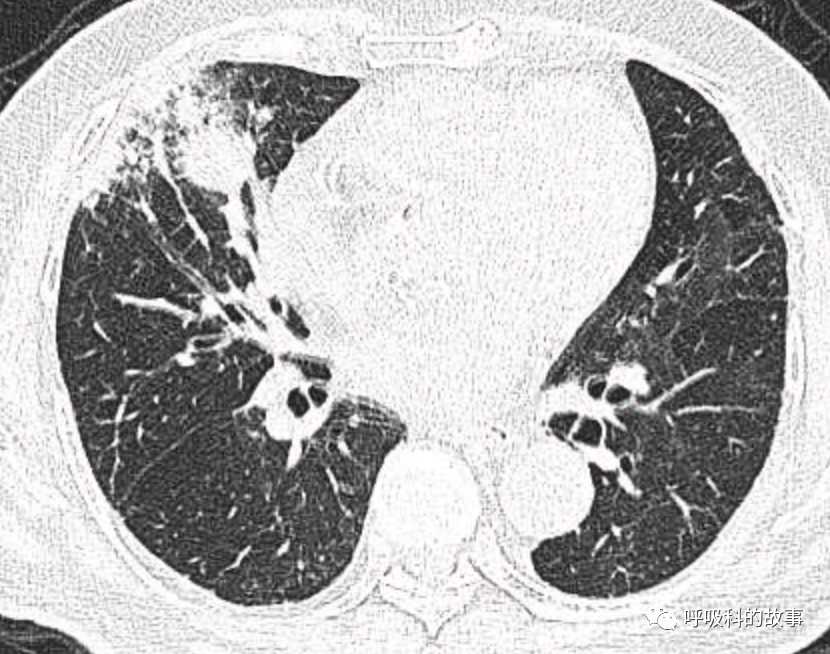
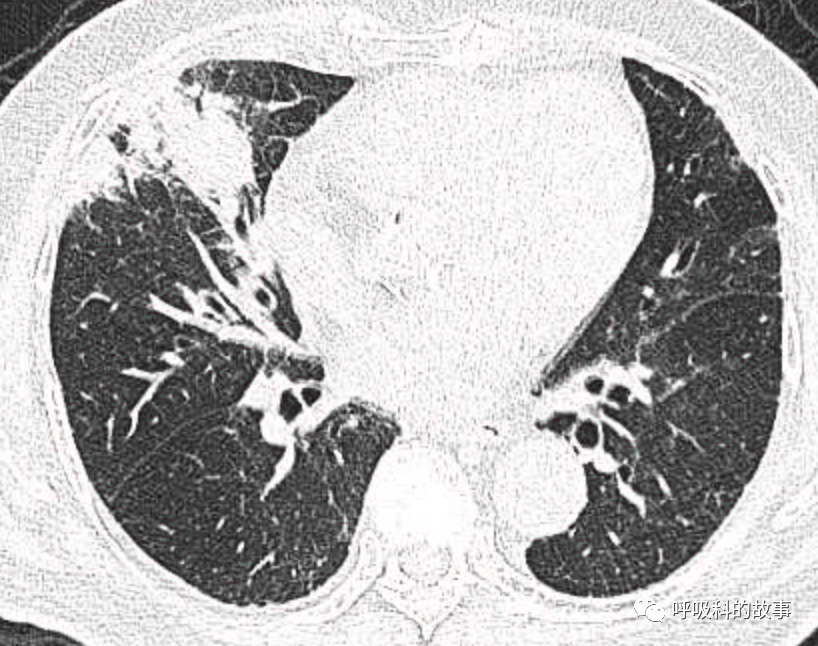
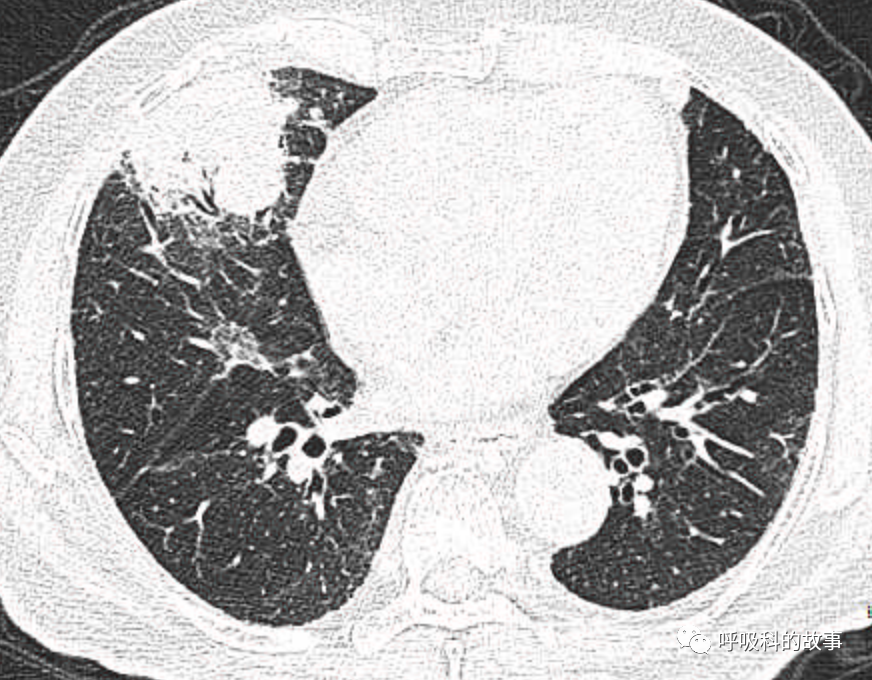
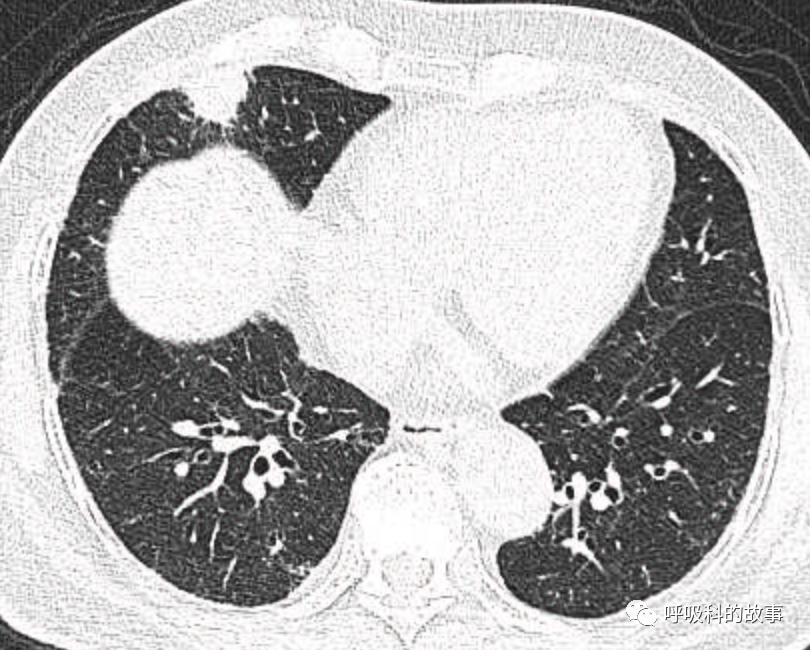
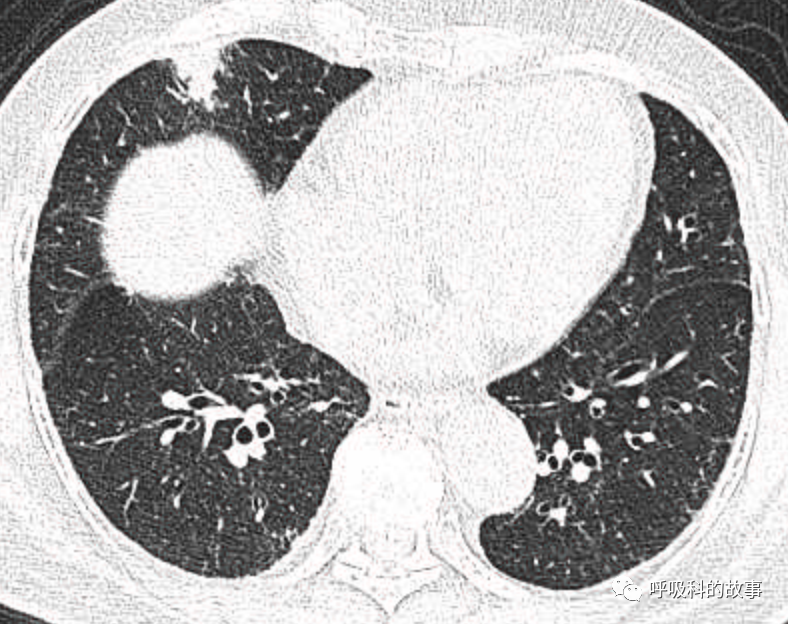

你知道吗?
延误治疗半年,只因少做这个检查
1个月前,我们收治了一个80多岁的男性患者,两肺多发结节和肿块,锁骨上淋巴结也触及肿大,在接诊时我们就预感不妙,患者很可能是患上了肺癌。后来经过穿刺后明确为大细胞神经内分泌癌,CT如下。

图1-11:该患者各个角度的影像图像
(上下滑动查看全部图片)
可是就在今年初,患者曾住在某院某科室,因为其他内科疾病住院。当时肺部CT也发现了在右中叶内侧段的高密度实变影,由于影像很类似肺炎,因此当成肺炎治疗。

图12-14:该患者各个角度的影像图像
(上下滑动查看全部图片)
当时出院也曾经嘱咐患者一个月后复查,但是患者由于没有症状,并未及时复查。我查阅了一下患者当时的肿瘤指标,非常可惜的是患者只进行了男性肿瘤五项的检测,其中与肺癌相关的只有癌胚抗原一项。而恰恰神经内分泌癌的癌胚抗原(CEA)通常是正常的。
上个月复查的肿瘤指标中,就有三项肺癌肿瘤指标增高:
男肿瘤五项(2021年1月):CEA:2.37μg/L(参考范围:0-5μg/L);
肺癌相关抗原(2021年4月):CEA:2.72μg/L,神经烯醇化酶(NSE):36.81μg/L(参考范围:0-16.6μg/L),细胞角蛋白19片段(CYFRA21-1):19.2μg/L(参考范围:0-3.5μg/L),鳞癌相关抗原(SCC):2.4μg/L(参考范围:0-1.5μg/L),胃泌素肽前体(ProGRP):42.13μg/L(参考范围:0-65μg/L)。
当然,我们无法懊悔当时为什么没有查肺癌抗原全套,也不确定当时的检查是否就一定会有异常,但是肿瘤标志物的检测在诊断肺癌中的确具有其特殊的临床价值。
肿瘤标志物在临床诊断中的价值
在发现肺部结节和肿块时,一定要进行肺癌相关肿瘤标志物的检测,能提高肺癌的诊断率。
曾经看到过一篇文献,是关于联合检测肿瘤标志物的临床价值,很值得大家一看。

图15 论文《Assessment of a Combined Panel of Six Serum Tumor Markers for Lung Cancer》 DOI: 10.1164/rccm.201404-0603OC
文中提到,通过我们详细询问病史结合影像分析结节或肿块特点来判断肺部肿块良恶性的准确性和单纯依靠肿瘤标志物的准确性程度相当,曲线下面积分别是0.85 vs 0.89。肿瘤标志物甚至略胜一筹。
但是如果将两者结合起来,曲线下面积可以增加到0.93,进一步提高了准确性。
不要小看了只是增加了0.04!肺癌发病率在我们国家每年几十万,那增加的绝对数也不容小觑。

图16 临床模型的接受者操作特征曲线(肿瘤大小、年龄和累积吸烟暴露)、此处检查的肿瘤标志物面板以及两者的组合用于诊断肺癌(注:AUC = 曲线下面积;CI = 置信区间;TM = 肿瘤标志物)
在这里,请大家牢记,肺癌相关的肿瘤标志物包括以下几个:
CEA;
NSE;
CYFRA21-1;
SCC;
ProGRP。
其中NSE和PorGRP这两个指标在鉴别小细胞肺癌(SCLC)与非小细胞肺癌(NSCLC)非常重要,而目前小细胞肺癌的发病率有所上升,需要我们重视。
下面这张图告诉我们在鉴别SCLC和NSCLC中,NSE和PorGRP水平相当(曲线下面积分别为0.894和0.861)。

图17 研究的六种肿瘤标志物的个体受试者操作特征曲线可区分非小细胞肺癌和小细胞肺癌(注:CA15.3 = 碳水化合物抗原 15.3)
当然,肿瘤标志物的临床应用要结合具体患者的情况,特别是肿瘤大小,可以理解的是如果肿瘤越大,肿瘤指标越可能出现异常,例如下图中,肿块直径大于3厘米时,肺癌患者的肿标异常情况达到88%,而非肿瘤患者的异常情况只有8%,非常有助于我们考虑和诊断肺癌。

图18 具有按结节大小分层的异常肿瘤标志物值的参与者(有和没有肺癌)的比例
当然也并不是肿瘤指标全部正常就能够完全排除肺癌。
研究者进一步分析数据发现,患者的肿块越大,如果出现任何一项肿瘤指标异常就高度增加肺癌的可能率。
如下图所示,在直径3厘米以上的肺部肿块中,如果有一项以上的肺癌相关抗原水平增高,那么其肺癌的比例高达99.2%,而所有肿标均正常肺癌的发生率只有40.5%。

图19 根据结节大小和异常肿瘤标志物(TM)值的存在/不存在,肺癌 (LC) 参与者的比例;P值(卡方检验)对应于红色(≥1 个异常 TM 值)和绿色(无异常 TM 值)列之间的比较
下面的表格可以更清楚地看到不同指标单个以及联合使用时其敏感性(SN)和特异度(SP)的情况,可以看出,联合检测在保证特异度没有明显下降的情况下,其敏感性有了大幅度地提高。

注:每个单独 TM 及其组合评估(≥1 个异常 TM)的敏感性、特异性、阳性预测值(PPV)和阴性预测值(NPV),按结节大小分层
小结:
在我国,肺癌发病率和死亡率均居恶性肿瘤首位,如何在临床实践中更好地利用这些指标是值得我们好好思考的。
也希望在我们遇到肺部肿块和实变等病变时,一定不要忘记鉴别肺癌。
参考文献:
[1]Molina R , Marrades R M , JM Augé, et al. Assessment of a Combined Panel of Six Serum Tumor Markers for Lung Cancer.[J]. American Journal of Respiratory and Critical Care Medicine, 2016:427-437.
本文来源:呼吸科的故事
审核专家:于江泳 北京医院
责任编辑:Owen
